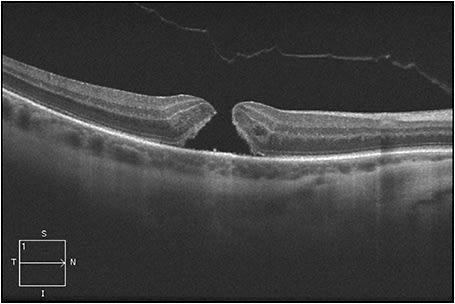

Surgery Following Use of Intravitreal Ocriplasmin
What factors should the surgeon consider?
LAUREN S. TANEY, MD • CAROLINE R. BAUMAL, MD
Anomalous posterior vitreous detachment refers to incomplete separation of the posterior vitreous cortex from the internal limiting membrane such that localized tractional deformities of the retina result.1 Attachment of the posterior vitreous cortex to the ILM is mediated by an extracellular matrix composed of glycoproteins and connective tissue molecules, such as collagen, laminin, and fibronectin.
When this extracellular matrix is unusually adherent to the underlying retina, vitreoretinal interface abnormalities ensue, including vitreomacular adhesion (VMA), vitreomacular traction (VMT), full-thickness macular hole (FTMH), and lamellar macular hole (LMH). Any of the above vitreoretinal interface abnormalities may be present with a concurrent epiretinal membrane.
Before 2012, surgical intervention with pars plana vitrectomy was the primary treatment modality for symptomatic vitreoretinal interface abnormalities. Nonsurgical, enzymatic vitreolysis emerged as an alternative treatment for symptomatic VMA (sVMA) when intravitreal ocriplasmin (Jetrea, ThromboGenics, Iselin, NJ) was approved by the FDA.
The Microplasmin for Intravitreous Injection–Traction Release without Surgical Treatment (MIVI-TRUST) study groups revealed that treatment with intravitreal injection of 0.125 mg of ocriplasmin resolved sVMA in 26.5% of eyes vs 10.1% of placebo-injected eyes (P<.001) by day 28.2 This determination was made using time-domain optical coherence tomography.
Lauren S. Taney, MD, practices with Washington Eye Physicians and Surgeons in Chevy Chase, MD. Caroline R. Baumal, MD, is associate professor of ophthalmology at the Tufts University School of Medicine, New England Eye Center, in Boston, MA. Neither author reports any financial interests in products mentioned in this article. Dr. Baumal can be reached via e-mail at cbaumal@tuftsmedicalcenter.org.
This study also revealed a statistically significant nonsurgical FTMH closure rate (in eyes with concurrent sVMA) of 40.6% vs 10.6% in, respectively, ocriplasmin-treated and placebo-treated eyes. For patients with vision loss attributable to an anomalous PVD, vitreolysis may be accomplished enzymatically or surgically.
In the MIVI-TRUST studies, factors predictive of a greater likelihood of successful sVMA release following intravitreal ocriplasmin use included focal VMA (≤1,500 µm), absence of ERM, age ≤65 years old, and phakic status. Independent studies performed since then have borne out the positive predictive value of these criteria, in some cases revealing a higher overall rate of successful VMT release with use of intravitreal ocriplasmin.3,4
Interestingly, complete sVMA release need not occur for FTMH closure to occur: in the phase 3 clinical studies, approximately one-half of those eyes experiencing FTMH closure did not display concurrent sVMA release on TD-OCT. Some studies have reported visual acuity gains without complete release of the VMT after intravitreal ocriplasmin.5
A single intravitreal ocriplasmin injection may be an alternative to surgery for a subset of eyes. However, PPV with gas may still be necessary in eyes that do not respond favorably after intravitreal ocriplasmin, such as those with unsuccessful VMT release, formation of a de novo FTMH, or persistence of a FTMH following ocriplasmin use. This article evaluates the perioperative issues that may accompany surgery following intravitreal ocriplasmin use.
PHASE 2 CLINICAL STUDIES
Ocriplasmin (formerly known as microplasmin) is a recombinant human protein with proteolytic properties, capable of cleaving peptide bonds in molecules such as fibronectin and laminin. Because fibronectin and laminin make up the extracellular matrix between the posterior vitreous cortex and the ILM, intravitreal injection of ocriplasmin alters the adhesion between these two structures and therefore enhances PVD formation.
Increased clinical experience with intravitreal ocriplasmin has helped to shed additional light on its function, as well as potential safety concerns. Much attention has focused on the rare occurrence of ellipsoid layer changes with retinal dysfunction, as documented with electroretinography.6-8 Very little, however, has been published on the topic of surgical outcomes following failed treatment with intravitreal ocriplasmin.
Study Data
Phase 2 studies on intravitreal microplasmin focused on its use in facilitating PVD formation in patients with VMT scheduled to undergo 20-gauge PPV. In the MIVI I trial, the primary outcome measurements were PVD induction as assessed using B-scan ultrasound, as well as the ease of PVD induction at the time of vitrectomy, which was analyzed using a grading scale designed to reflect the amount and duration of mechanical manipulation needed to create a PVD intraoperatively: vitrector suction settings were set to begin at 40 mm Hg for 30 seconds, with sequential advancement to suction settings of either 80 mm Hg for 30 seconds or 120 mm Hg for 30 seconds or higher, if PVD formation was not achieved at a level of lower suction settings.
The study revealed that a higher dose and increased exposure time to intravitreal microplasmin resulted in: (1) a higher percentage of PVD formation prior to PPV, as assessed on B-scan; and (2) easier PVD induction, requiring less suction, at the time of PPV in those patients without PVD formation prior to surgery.
Vitreoschisis was noted intraoperatively in patients receiving the highest doses and longest exposure times to microplasmin: although preoperative B-scan revealed the presence of a PVD in these cases, subtotal dehiscence of the vitreous from the optic nerve, with any additional layer of vitreous present that required deliberate removal, was noted intraoperatively.9
An additional phase 2 study also compared maximum suction and total surgical time involved in PVD induction following intravitreal ocriplasmin. It found the mean maximum suction to be 294, 239, 211, and 200 mm Hg between, respectively, placebo and 25 µg, 75 µg, and 125 µg of microplasmin. It also found the mean surgical time spent on PVD induction to be 184, 100, 119, and 116 seconds between, respectively, placebo and 25 µg, 75 µg, and 125 µg of microplasmin.10
In this study, 54 patients had FTMH prior to treatment with microplasmin (at varying doses), and although 10 of 18 patients achieved both successful nonsurgical VMT release and FTMH closure with intravitreal ocriplasmin, ultimately 44 went on to need PPV after use of intravitreal ocriplasmin.
These two studies provided some objective data about the quality of the vitreous during PPV following intravitreal ocriplasmin, suggesting that creation of a PVD intraoperatively is both generally easier and faster in this subset of patients. Most vitreoretinal surgeons, however, do not report noticing a qualitative change in the consistency of the vitreous during PPV in those eyes previously receiving intravitreal ocriplasmin.11
FTMH CLOSURE RATES
Previous reports of spontaneous FTMH closure rates have ranged from 5% to 11.5%.12-14 In the phase 3 MIVI-TRUST studies, FTMH closure rate by day 28 following intravitreal ocriplasmin was a secondary outcome. Closure rates for eyes with FTMH with concurrent sVMA varied depending on FTMH size. For small (≤250 µm) FTMH, 58.3% vs 16.0% achieved closure following, respectively, treatment with intravitreal ocriplasmin and placebo (P<.001). For medium (>250 µm and ≤400 µm) FTMH, 36.8% vs 5.3% were closed following, respectively, treatment with intravitreal ocriplasmin and placebo (P=.009).15
No large FTMHs (>400 µm) were successfully closed using intravitreal ocriplasmin. In those eyes achieving FTMH closure following intravitreal ocriplasmin, only 9.3% experienced FTMH reopening at month 6, which may possibly be attributed to complex tractional forces exerted by the ILM.
In the MIVI-TRUST studies, 17.7% of eyes receiving intravitreal ocriplasmin (vs 26.6% of eyes receiving placebo) required vitrectomy at month 6.2 A subset of those patients requiring vitrectomy after intravitreal ocriplasmin were those eyes with FTMH and concurrent sVMA that did not achieve FTMH closure following intravitreal ocriplasmin. FTMHs were successfully closed by secondary surgical repair in 37 of these 47 eyes (78.7%), with 12 of 37 eyes (32.4%) gaining at least 2 ETDRS lines at six months.16
This reported FTMH closure rate via vitrectomy after intravitreal ocriplasmin is consistent with reported rates of FTMH closure rates via primary vitrectomy, which may range from 76% to 88%.17,18 This finding suggests that use of intravitreal ocriplasmin does not adversely impact the success rate of FTMH anatomic closure with subsequent PPV.
Our Findings and Other Studies
We conducted a retrospective chart review at the New England Eye Center to evaluate the surgical and VA outcomes of patients with unresolved FTMH after treatment with intravitreal ocriplasmin, who subsequently underwent vitrectomy.
Four eyes of four patients with small or medium FTMH with associated focal VMT were included in this retrospective analysis. Following intravitreal ocriplasmin, focal VMT release occurred by four days after injection in all four eyes, and the FTMH aperture size increased without closure in all cases.
Figure 1 shows an eye in this series, with FTMH measuring 216 µm and concurrent focal VMT; this patient’s best-corrected Snellen VA was 20/70. Figure 2 shows VMT release following intravitreal ocriplasmin, with a decrease in VA to 20/200 at one week following injection. Figure 3 demonstrates an increase in FTMH size (now measuring 264 µm) at 12 days following injection.

Figure 1. An eye from the series at the New England Eye Center, with FTMH measuring 216 µm and concurrent focal VMT; this patient’s best-corrected Snellen visual acuity was 20/70.

Figure 2. VMT release following intravitreal ocriplasmin, with a decrease in VA to 20/200 at one week following injection.
Figure 3. An increase in FTMH size (now measuring 264 µm) occurred at 12 days following injection.
In this series, all of the eyes subsequently went on to PPV with indocyanine green–assisted ILM peel, endolaser, and sulfur hexafluoride tamponade at 10 days to eight weeks following ocriplasmin. During PPV, all four eyes required intraoperative laser for peripheral retinal pathology. The surgeons did not notice any differences in the quality of the vitreous intraoperatively, compared with non–ocriplasmin-treated eyes.
Following PPV, all of the FTMHs were successfully closed, and vision improved in three of four eyes. Vision did not improve in one eye following PPV, which may be attributed to the development of a macula-off rhegmatogenous retinal detachment within 10 days of intravitreal ocriplasmin.19
Figure 4 (page 50) shows FTMH closure one month following PPV, with a VA of 20/30 at this time. Figure 5 (page 50) shows the same eye almost one year following PPV: the FTMH remained closed with mild attenuation of the subfoveal ellipsoid zone, and the vision remained stable.

Figure 4. FTMH closure is seen one month following PPV, with a VA of 20/30 at this time.

Figure 5. Almost one year following PPV, the FTMH remained closed with mild attenuation of the subfoveal ellipsoid zone, and the vision remained stable.
Although limited by its small study size and retrospective nature, this review concluded that failure of FTMH closure using intravitreal ocriplasmin did not affect the anatomic success of eventual FTMH closure via PPV.
Another retrospective study from Wills Eye Hospital reported surgical outcomes in eyes requiring PPV following failed FTMH closure with ocriplasmin. In this study, all 10 eyes that had PPV for persistent FTMH following ocriplasmin went on to successful FTMH anatomic closure, with the time interval to PPV ranging from 22 to 80 days.4
A prospective study in the United Kingdom also recently published similar findings in terms of surgical success rates following intravitreal ocriplasmin. A total of 12 patients with FTMHs <400 µm with concurrent VMT were treated with intravitreal ocriplasmin. FTMHs closed in three of 12 eyes, but FTMHs remained open in the remaining nine eyes. The size of the FTMH increased by at least 100 µm in four of the nine eyes. All nine eyes went on to PPV within four to nine weeks of ocriplasmin injection, and FTMHs were anatomically closed following PPV in all cases.20
Additionally, some investigators are evaluating the use of expansile gas injection following persistent FTMH despite VMT release following use of intravitreal ocriplasmin. This procedure may also be an additional surgical adjunct, but such clinical data are not yet available.
CONCLUSION
Increased clinical experience with intravitreal ocriplasmin will enhance our understanding of this drug’s role in the management of vitreomacular interface disorders. It does not currently appear that prior utilization of intravitreal ocriplasmin adversely impacts anatomic or visual outcomes in eyes that may require subsequent PPV.
Clinical studies have suggested that previous intravitreal ocriplasmin injection may impact the ease and speed of subsequent vitrectomy. Complex vitreoretinal interface abnormalities may contribute to enlargement of FTMH size following intravitreal ocriplasmin, as well as to the development of peripheral retinal pathology requiring repair.
Larger clinical studies may further define the optimal candidates for intravitreal ocriplasmin vs PPV for the management of vitreomacular interface disorders. RP
REFERENCES
1. Duker JS, Kaiser PK, Binder S, et al. The International Vitreomacular Traction Study Group classification of vitreomacular adhesion, traction, and macular hole. Ophthalmology. 2013;120:2611-2619.
2. Stalmans P, Benz MS, Gandorfer A, et al. Enzymatic vitreolysis with ocriplasmin for vitreomacular traction and macular holes. N Engl J Med. 2012;367:606-615.
3. Singh RP, Li A, Bedi R, et al. Anatomical and visual outcomes following ocriplasmin treatment for symptomatic vitreomacular traction syndrome. Br J Ophthalmol. 2014;98:356-360.
4. Sharma P, Juhn A, Houston SK, et al. Efficacy of intravitreal ocriplasmin on vitreomacular traction and full-thickness macular holes. Am J Ophthalmol. 2015;159:861-867.
5. Jeng KW, Baumal CR, Witkin AJ, et al. Incomplete release of vitreomacular attachments after intravitreal ocriplasmin. Ophthalmic Surg Lasers Imaging Retina. 2015;46:271-274.
6. Tibbetts MD, Reichel E, Witkin AJ. Vision loss after intravitreal ocriplasmin: correlation of spectral-domain optical coherence tomography and electroretinography. JAMA Ophthalmol. 2014;132:487-490.
7. Johnson MJ, Fahim AT, Rao RC. Acute ocriplasmin retinopathy. Retina. 2015;35:1055-1058.
8. Kim JE. Safety and complications of ocriplasmin: Ocriplasmin, ocriplasmin; Oh, how safe art thou? JAMA Ophthalmol. 2014;132:379-380.
9. de Smet MD, Gandorfer A, Stalmans P, et al. Microplasmin intravitreal administration in patients with vitreomacular traction scheduled for vitrectomy: the MIVI I Trial. Ophthalmology. 2009;116:1349-1355.
10. Benz MS, Packo KH, Gonzalez V, et al. A placebo-controlled trial of microplasmin intravitreous injection to facilitate posterior vitreous detachment before vitrectomy. Ophthalmology. 2010;117:791-797.
11. Garg S. Vitrectomy after ocriplasmin for vitreomacular traction or macular hole (VAVOOM) study. Paper presented at: Annual meeting of the American Society of Retina Specialists; San Diego, CA; August 9-13, 2014.
12. Guyer DR, de Bustros S, Diener-West M, Fine SL. Observations on patients with idiopathic and macular holes and cysts. Arch Ophthalmol. 1992;110:1264-1268.
13. Ezra E, Gregor ZJ; Moorfields Macular Hole Study Group. Surgery for idiopathic full-thickness macular hole: two-year results of a randomized clinical trial comparing natural history, vitrectomy and vitrectomy plus autologous serum: Moorfields Macular Hole Study Group Report No. 1. Arch Ophthalmol. 2004;122:224-236.
14. Chew EY, Sperduto RD, Hiller R, et al. Clinical course of macular holes: The Eye Disease Case-Control Study. Arch Ophthalmol. 1999;117:242-246.
15. Haller JA, Stalmans P, Benz MS, et al. Efficacy of intravitreal ocriplasmin for treatment of vitreomacular adhesion: Subgroup analyses from two randomized trials. Ophthalmology. 2015;122:117-122.
16. Dugel PU, Regillo C, Eliott D. Characterization of anatomic and visual function outcomes in patients with full-thickness macular hole in ocriplasmin phase 3 trials. Am J Ophthalmol. 2015;160:94-99.
17. Parravano M, Giansanti F, Eandi CM, et al. Vitrectomy for idiopathic macular hole. Cochrane Database Syst Rev. 2015;5:1-34.
18. Hoerauf H. Predictive values in macular hole repair. Br J Ophthalmol. 2007;91:1415-1416.
19. Lee GD, Taney LS, Rogers AH, et al. Surgical outcomes for persistent macular hole after ocriplasmin. Ophthalmic Surg Lasers Imaging Retina. 2015;46:732-736.
20. Steel DHW, Sandinha MT, White K. The plane of vitreoretinal separation and results of vitrectomy surgery in patients given ocriplasmin for idiopathic macular hole. Invest Ophthalmol Vis Sci. 2015;56:4038-4044.








